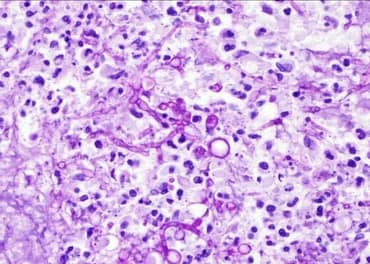
PAS-D positive Aspergillus fungal Hyphae

The Periodic Acid-Schiff (PAS) stain is a histological staining technique used to detect carbohydrates and glycogen in tissue sections. It is based on the reaction between periodic acid and carbohydrates, followed by the reaction with Schiff’s reagent. This results in the formation of a bright pink to magenta-colored complex that highlights the presence of carbohydrates.
what is principle of PAS stain?
- Periodic acid oxidizes the vicinal diols in carbohydrates, creating aldehydes.
- Schiff’s reagent reacts with the aldehydes to form a magenta-colored complex.
- The magenta-colored complex is insoluble in water, so it is retained by the tissue sections
What is composition of PAS stain?
The composition of PAS stain varies with the manufacturer, but it typically includes
- Periodic acid Solution (0.5%)
- Schiff’s reagent: This is a mixture of basic fuchsin and hydrochloric acid. sodium metabisulfite, which is used to quench the Schiff’s reagent and prevent it from continuing to react with the aldehydes.
- Hematoxylin
How to prepare PAS stain?
For 0.5 % periodic acid solution – Dissolve 1gm periodic acid in 200ml distilled water
schiff’s reagent preparation-
Step 1- Dissolve 1gm Basic fuschin in 200ml boiling distilled water.
step 2 -when dissolved cool it to 50-60 degree celsius then add 2gm of pottasium metabisulphite and mix
step 3 -bring mixture to room temperature , now add 2ml Hydrochloric acid and mix.
step 4 – Next step is to add 2gm of activated charcoal .keep this chemical solution at room temperature in dark place overnight. filter it next morning. Ideal solution colour Should be pale yellow to clear . store the solution at 2-8 degree in Dark container
what is principle of PAS stain?
- Periodic acid oxidizes the vicinal diols in carbohydrates, creating aldehydes.
- Schiff’s reagent reacts with the aldehydes to form a magenta-colored complex.
- The magenta-colored complex is insoluble in water, so it is retained by the tissue sections
PAS stain primarily detects the following substances:
- Polysaccharides: PAS stain is commonly used to identify polysaccharides, with glycogen being the most prominent polysaccharide observed in human and animal tissue sections. Glycogen is present in various tissues, including skeletal muscle, cardiac muscle, liver, and kidney.
- Neutral mucus substances: PAS stain is effective in staining and identifying neutral mucus substances. These substances include glycoproteins, glycolipids, and neutral mucins, which are produced by epithelial cells in different organs.
- Tissue basement membranes: PAS stain helps visualize and distinguish tissue basement membranes. These are thin layers of reticular connective tissue that provide support and anchorage for epithelial and endothelial cells to the underlying connective tissue.
- Fungal organisms: PAS stain can also detect fungal organisms. Some fungal cell walls contain high levels of carbohydrates, making them PAS-positive. This allows for the identification and localization of fungal elements in tissue samples
By highlighting these substances, PAS stain provides valuable insights into the composition and structure of tissues, aiding in the diagnosis and understanding of various pathological conditions.
Procedure of PAS staining :
1. Deparaffinize the sections and bring the sections to water.
2. Oxidize in 0.5% Periodic Acid solution for 5 to 10 minutes.
3. Rinse in distilled water for 5 minutes.
4. Place in Schiff’s reagent for 15-20 minutes (Sections become light pink color during this step).
5. Wash in tap water for 5 minutes (Sections immediately turn dark pink).
6. Counterstain in Mayer’s or harris hematoxylin for 1 to 5 minutes, depending on preference of nuclear stain intensity.
7. Wash in tap water for 5 minutes then rinse in distilled water.
8. Dehydrate by rinsing in alcohol, clear with xylene dips
9. coverslip and mount using mounting media
Test for Schiff’s reagent:
To test Schiff’s reagent, pour 10 mL of 10% formalin into a beaker and add a few drops of the Schiff’s reagent to be tested. If the Schiff’s reagent is good, it will rapidly turn a red-purple color. If the Schiff’s reagent is deteriorating, it will give a delayed reaction and the color produced will be a deep blue-purple.
Internal control for PAS stain-
- Kidney is most sensitive
- Liver should be used when glycogen demonstration is required
Clinical Uses of PAS Stain
- Diagnosing glycogen storage diseases: Glycogen storage diseases are a group of inherited disorders that cause the accumulation of glycogen in tissues. PAS stain can be used to visualize the glycogen deposits in tissues, which can help to diagnose these disorders. liver biopsy is commonly done for diagnosis of glycogen storge disorders.
- Diagnosing mucopolysaccharidoses: Mucopolysaccharidoses are a group of inherited disorders that cause the accumulation of mucopolysaccharides in tissues. PAS stain can be used to visualize the mucopolysaccharide deposits in tissues, which can help to diagnose these disorders.
- Diagnosing fungal infections: Fungi contain polysaccharide laden fungal cell walls and PAS stain can be used to visualize the fungal hyphae and spores in tissues. This can help to diagnose fungal infections.


- Demonstrating basement membranes: Basement membranes are thin layers of extracellular matrix that separate epithelial cells from underlying tissues. PAS stain can be used to visualize basement membranes, Particularly helpful in Renal biopsies for distinguishing tubulitis (in allograft), diabetic Kimmelstiel-Wilson nodules (PAS positive) ,and screening for amyloid

- Demonstrating mucins: Mucins are glycoprotein that are produced by cells in the lining of the respiratory, gastrointestinal, and reproductive tracts. PAS stain can be used to visualize mucins, which can help to identify different types of tissues.
- Diagnosis of various Tumors: Adenocarcinoma of various sites are mucin secreting tumours , apocrine carcinomas, diagnosis of basement membrane containing tumors like cylindroma, eccrine spiradenoma, clear cell tumors (stains glycogen),diagnosis of salivary gland tumours like Acinic cell carcinoma which contain plenty of zymogen granules.
What is PAD Diastase(PAS-D) staining method?
PAS-D is a combination of the Periodic Acid-Schiff (PAS) stain and diastase digestion it is a staining method used in histology to differentiate glycogen from other PAS-positive elements in tissue samples.
Diastase (or a-amylase) an enzyme that breaks down glycogen. When diastase is added to a tissue sample that has been stained with PAS, the glycogen will be digested and the magenta staining will be lost. This allows the pathologist to distinguish glycogen from other PAS-positive elements in the tissue, such as mucins and basement membranes.
Result–After diastase digestion, the glycogen will be absent or only weakly stained. Other PAS-positive and diastase resistant elements, such as mucins and basement membranes, will still be stained magenta.
PAS-D is a useful staining method for diagnosing a variety of conditions, including:
- Alpha-1 antitrypsin deficiency-The PAS-D test can identify abnormal alpha-1-anti-trypsin globules in the liver, a sign of alpha-1-anti-trypsin deficiency.

- Whipple’s disease-Whipple’s disease is caused by T. whipplei bacteria. PAS-D test on small bowel tissue samples can help diagnose the disease by highlighting histiocytes found in large numbers in Whipple’s disease.
- Fungal elements-PAS-D staining can highlight fungal micro-organisms like Aspergillosis ,Candida and Pneumocystis, making them appear bright pink or red under a microscope. This helps pathologists identify and diagnose fungal infections.
what is difference between PAS and PAS Diastase (PAS-D)?
PAS does not include diastase, while PAS-D does. Glycogen appears pink on the PAS stained slide but clear on the PAS-D stained slide, which allows pathologists to differentiate between glycogen and other PAS-positive substances.
1 thought on “PAS stain : Principle, Procedure, uses”